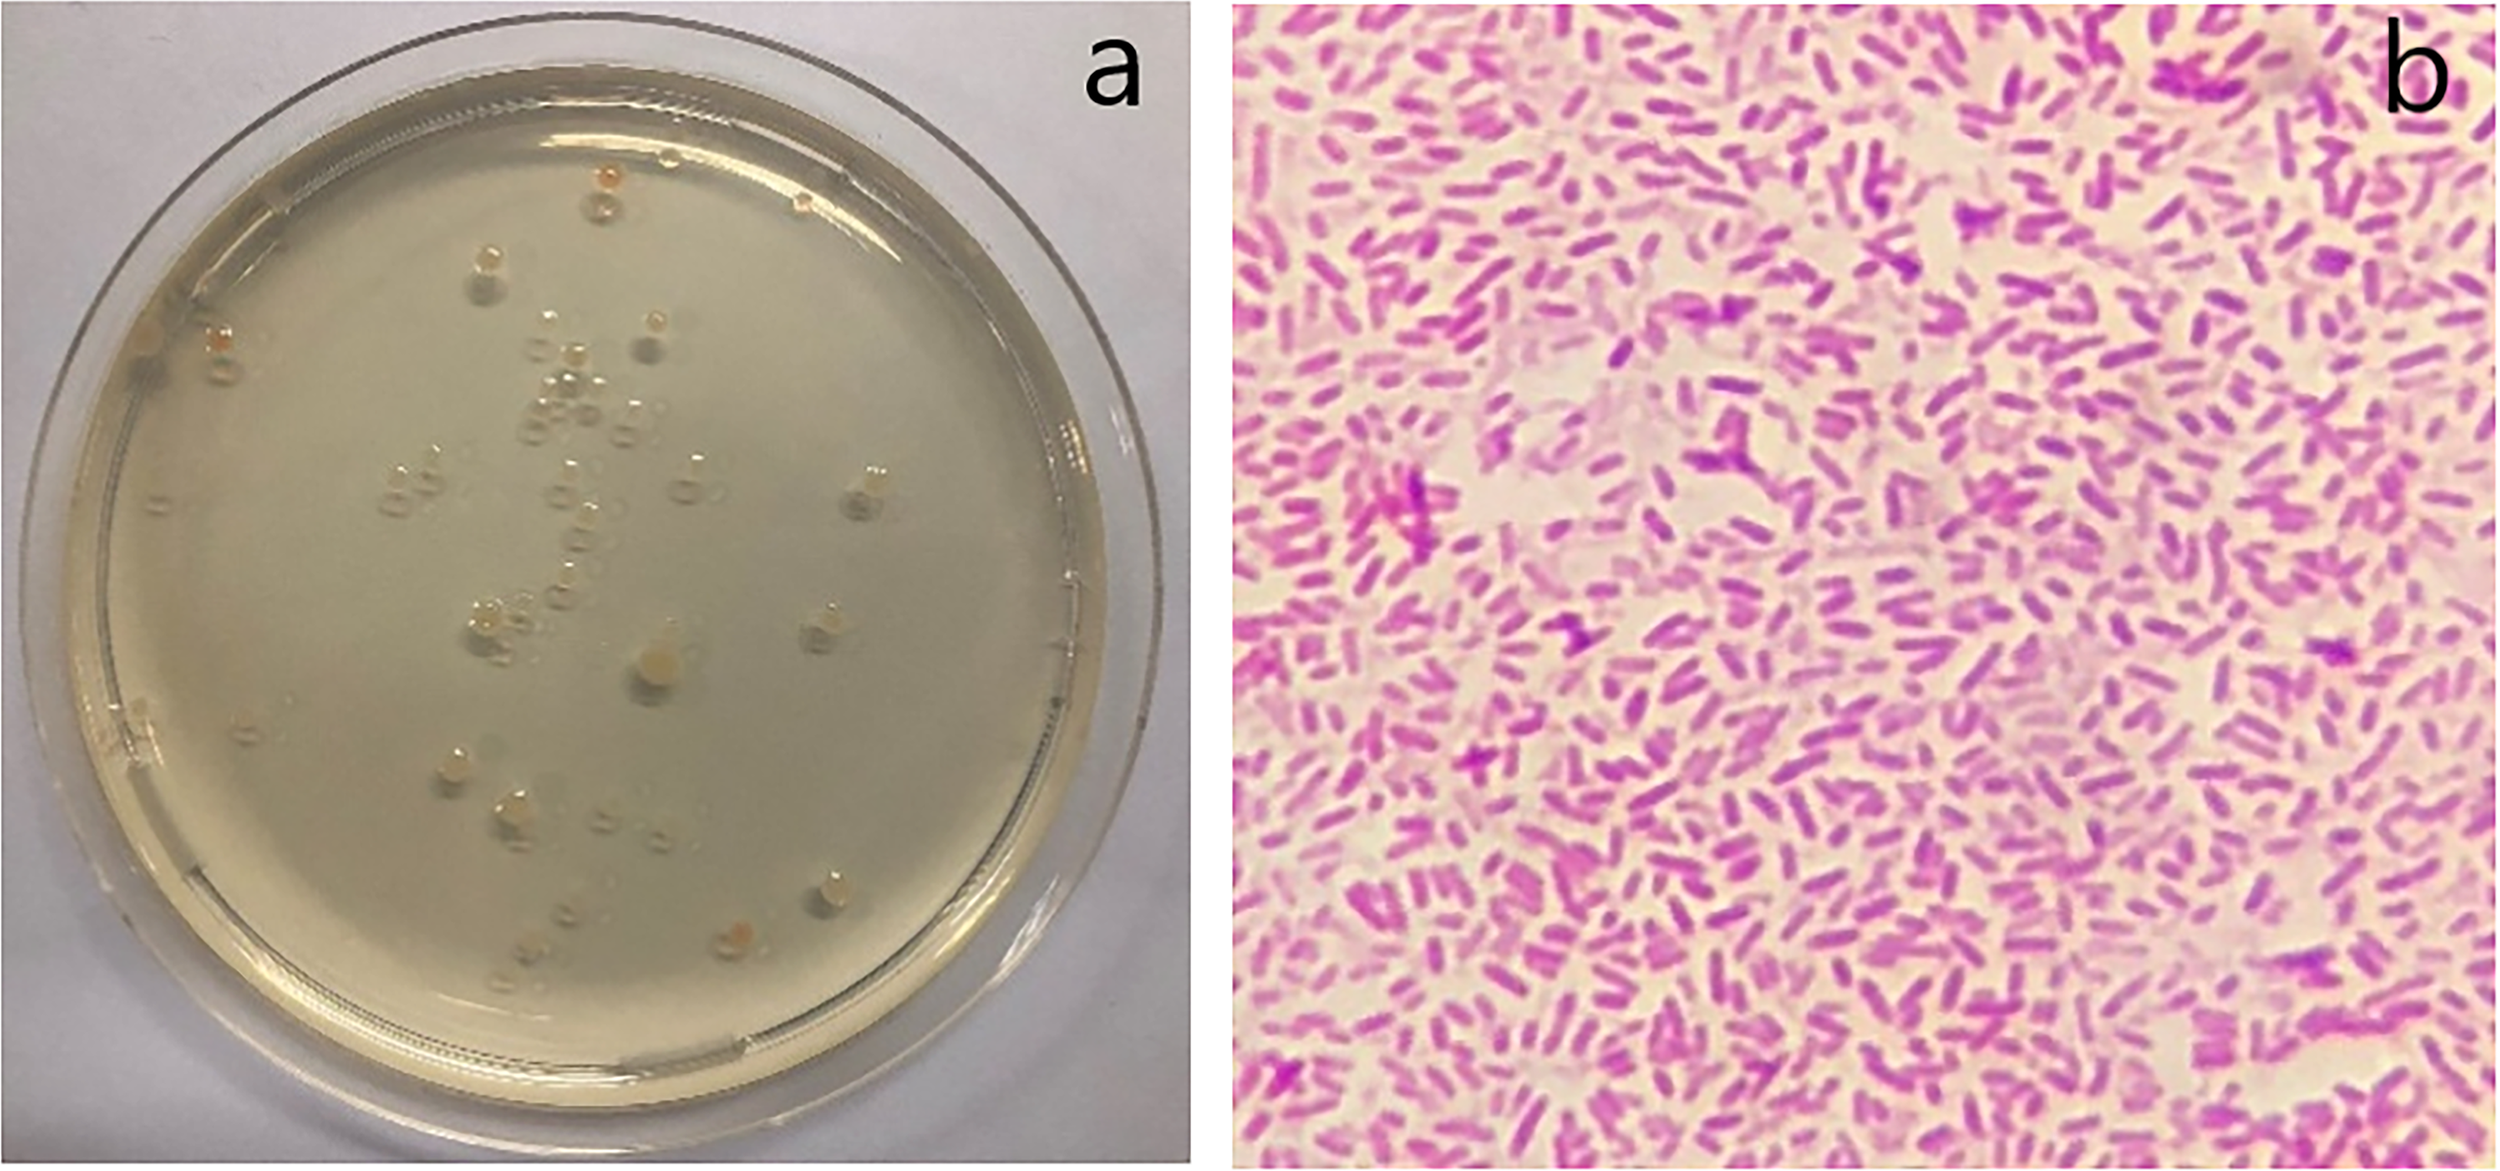
Figure 5

Abstract
The waste created by single-use plastics is an important global issue, especially in marine environments, because they do not degrade in nature. This work aimed to study the biodegradability of bioplastic blown film, which may pose a solution to this problem. Polybutylene succinate (PBS) and polylactic acid (PLA) blown films were chosen for examination of their biodegradability when submerged in sand under the seawater and when floated on the seawater surface of our experimental setup. Bioplastics were observed in comparison with low-density polyethylene (LDPE), which is a petroleum-based plastic. PBS blown film exhibited a faster degradation rate than PLA blown film, while LDPE blown film did not degrade in the marine environment. The biodegradability of bioplastic blown film was confirmed by physical observation, a change in the chemical functional group measured by Fourier-transform infrared spectroscopy, and a test of the biochemical oxygen demand of the seawater after bioplastic degradation due to ingestion by bacteria in seawater.
Introduction
In recent years, the use of petroleum-based plastics in our daily lives has become a critical environmental issue because they are only used for a short period but take a long time to degrade in nature. This problem of plastic waste management has encouraged many countries to seek a solution to reduce the use of petroleum-based plastics (Geyer et al., 2017; Rhodes, 2018; Borrelle et al., 2020; Lau et al., 2020). Plastic pollution is a problem not only on land but also in the marine environment because of its resistance to degradation (Joyner and Frew, 1991; Eriksen et al., 2014; Jambeck Jenna et al., 2015; Haward, 2018; Lebreton et al., 2018; Stafford and Jones, 2019; Ross et al., 2021). Most plastics that pass through the ocean affect marine animals, which ingest them as small plastic pieces that can accumulate in their cells and organs after digestion (Coleman and Wehle, 1984; Wabnitz and Nichols, 2010; Sigler, 2014; Vegter et al., 2014; Wilcox et al., 2016; Avio et al., 2017). Plastics in the digestive systems of aquatic animals can cause harm or even animal death. This could also pose a problem for human health because humans might consume contaminated aquatic animals in their daily diet (Pahl et al., 2017; Rhodes, 2018; Awuchi and Awuchi, 2019; Akindele and Alimba, 2021; Alfaro-Núñez et al., 2021; Mukheed and Khan, 2021). In Thailand, studies have been conducted on microplastics in marine fishes (Klangnurak and Chunniyom, 2020) and aquatic fishes (Kasamesiri, 2021)and found that microplastics or nanoplastics could pass through the food chain to the human body, thus affecting future human health.
The use of bioplastics in place of petroleum-based plastics is one way to solve this problem, especially in the case of single-use plastics, because they can be degraded by bacteria under appropriate conditions (Peelman et al., 2013; Yen et al., 2013; Mizuno et al., 2015; Pelegrini et al., 2015; Morawska and Krasowska, 2017; Bubpachat et al., 2018). There are two main types of commercial bioplastics purchased from industries, namely, polylactic acid (PLA) and polybutylene succinate (PBS). Previous studies of these two types of bioplastics can be found, especially for blown plastic film packaging (Peelman et al., 2013; Mallet et al., 2014; Su et al., 2019; Palai et al., 2020). Although the biodegradability of PLA (Morawska and Krasowska, 2017; Bubpachat et al., 2018), PBS (Mizuno et al., 2015), and their blends (Muthuraj et al., 2018) in the soil has been studied, few studies on the biodegradability of these bioplastics in the marine environment have been conducted—for example, Pelegrini et al. (2015) investigated the biodegradability of PLA composite with natural fiber in a marine environment. They found a high degradation rate when the amount of natural fiber was increased because the natural fiber absorbed water, which accelerated the hydrolytic degradation rate. Xu and Guo (2010) and Mochane et al. (2021) investigated the biodegradability of a PBS composite with natural fibers in a lipase solution, soil, water, activated sludge, and other composts. However, to the best of our knowledge, there is no research on the biodegradability of these two types of bioplastic blown films compared to that of petroleum-based plastics in a marine environment. Thus, this research aimed to explore the biodegradability of PLA and PBS blown films compared to that of low-density polyethylene (LDPE) blown film, which is a petroleum-based product commonly used in single-use plastics. The degradation rate of virgin PLA and PBS blown film was observed by photography and weight loss. The degradation mechanism was confirmed by Fourier-transform infrared spectroscopy (FTIR) and biochemical oxygen demand (BOD) assay.
Materials and methods
Materials
LDPE (LL7810A Grade, PTT Global Chemical, Co., Ltd., Thailand), PLA (2003D Grade, Nature Works, USA), and PBS (FZ91PM Grade, PTT MCC Biochem Co., Ltd., Thailand) were fabricated as thin films by a laboratory blown film process (XH-430A, Xihua Testing Machines, Co., Ltd., China). The thickness of the sample of blown film was approximately 30–40 µm. The plastic film was cut into a square sheet with dimensions of 3 × 3 cm2 for biodegradation experiments in a marine environment. Seawater and sand were collected from Bangsaen Beach, Chonburi Province, Thailand (13.2835 latitude and 100.9151 longitude) without further purification. The seawater had 40% salinity and a pH of 6.8 (as of November 2018). An ultraviolet A (UVA) light source [Sankyo UVA, intensity of 10 W, 0.9 mW/cm2 (78 mJ/cm2), CCS Sucessesproducts, Co., Ltd., Thailand] with a length of 35 cm was used to accelerate the degradation rate of bioplastics. Potassium bromide (KBr, 100% purity) was purchased from Thermo Fisher Scientific. Other chemicals, such as manganese sulfate (MnSO4), sodium hydroxide (NaOH), sodium iodide (NaI), sulfuric acid (H2SO4), sodium thiosulfate (Na2S2O3), sodium azide (NaN3), potassium biiodate [KH(IO3)2], and cornstarch, were of commercial grade.
Experimental setup of bioplastic degradation in a marine environment
Six fish tanks with dimensions of 25 × 50 × 30 cm3 were established as a prototype model of the marine environment. The UVA light source (35 cm in length) was set at the top of each fish tank to generate ultraviolet (UV) radiation. UVA was used to accelerate the biodegradability of bioplastics caused by photodegradation. In addition, the UVA light source was connected to an automatic timer switch that was open in the daytime (6 am–6 pm) and closed at night to simulate natural solar UV radiation. The seawater and sand were collected without further purification because we wanted to replicate the natural beach environment. The water was continuously aerated to guard against water pollution during the experiment. Blown plastic film with a thickness of approximately 30–40 µm was divided into two experimental conditions. Blown plastic films of all types were submerged in the sand under the seawater and floated on the seawater surface in separate fish tanks. The experimental setup for biodegradable testing is shown in Figure 1. In addition, blown plastic films of LDPE, PLA, and PBS that were submerged in the sand under the seawater and floated on the seawater surface were collected every 2 weeks to observe the morphological change and weight loss from each type of plastic sheet.
Figure 1

Experimental setup of biodegradable bioplastics under marine environment.
Biochemical oxygen demand method
BOD was measured according to the ISO 5815 standard. This standard determines the biochemical oxygen demand of a water sample before and after 5 days (BODn) of incubation (Jouanneau et al., 2014). The standard test was performed on microbial samples from the environment without further purification. The pH of the sample was adjusted to between 6 and 8 with hydrochloric acid (1 M) solution or sodium hydroxide (1 M) solution. Then, the sample was oxygenated with an oxygen gas generator and poured into the BOD standard bottle, and any possible supersaturation of oxygen was eliminated by slowly shaking the BOD standard bottle. The bottle was incubated at 20 ± 2°C for 5 days, and the dissolved oxygen in the sampled water was tested on the first and fifth days after incubation following the ISO 5815 standard testing method.
Characterization
Samples of blown plastic film, collected every 2 weeks, were photographed with a mobile phone camera (iPhone SE, Apple Inc., USA), and the weight of the film sheet was determined after drying in an oven at 80°C overnight. Microplastics in the seawater after degradation (54 weeks for PBS and 80 weeks for PLA) were observed with an optical microscope (BX53, Olympus, USA) using Image J software and statistical methods to calculate the particle size and particle size distribution of 200 particles of each sample. The plastic sample was blended well with KBr powder before and after degradation. The plastic sample after degradation was washed in DI water to remove the salt and contaminants in the seawater before testing. The sample was pressed into a pellet with a hydraulic press. Then, the functional chemical structure was characterized by FTIR (iS50 FT-IR, Thermo Fisher Scientific Inc., USA) in attenuated total reflection (ATR) mode. The seawater was observed, without further purification, for bacterial growth in cell culture. After incubation and growth, the bacteria were stained with dye (Giuliano et al., 2019) and examined under an optical microscope (BX53, Olympus, USA) to confirm the type of bacteria that could accelerate the degradation of bioplastics in seawater. After the biodegradation test in the fish tank, the BOD of the sampled seawater was analyzed following the ISO 5815 standard.
Results and discussion
Biodegradability of polybutylene succinate and polylactic acid
The morphological changes in the blown plastic films were observed by sampling the films every 2 weeks. Tables 1, 2 outline the physical changes in LDPE, PBS, and PLA that were floated on the seawater surface and submerged in the sand under the seawater in our experimental setup. The mechanism of bioplastic biodegradation by microorganisms after hydrolysis by water was confirmed by previous studies (Hakkarainen, 2002; Kim and Kim, 2008; Pelegrini et al., 2015; Elsawy et al., 2017). Whitening of the PBS blown film was observed after 22 weeks, and the color of PBS that was floated on the seawater surface changed faster than that of PBS submerged in the sand under the seawater. This may be because the PBS blown film that was floated on the seawater surface contacted the seawater with the entire surface area of the plastic film; thus, it could be degraded faster by bacteria and hydrolytic mechanisms than the PBS blown film that was submerged in the sand under the seawater. Whitening of the plastic sheet occurred due to degradation of the amorphous phase by scissoring of polymer molecules, resulting in only the crystalline structure of the polymer molecules remaining at the beginning of the period of biodegradation (Peelman et al., 2013; Yen et al., 2013; Mizuno et al., 2015; Pelegrini et al., 2015; Morawska and Krasowska, 2017; Bubpachat et al., 2018). The PBS blown film that was floated on the seawater surface disappeared after 54 weeks, while that submerged in the sand under the seawater disappeared 4–8 weeks later. The LDPE blown film did not degrade, and some algae was observed on the surface after a long experimental period, as seen in Tables 1, 2, while the PLA blown film (Table 2) began cracking into small pieces after 56 weeks when floated on the seawater and after 66 weeks when submerged in the sand under the seawater. Unfortunately, the sample of PLA blown film was not enough for a complete degradation test due to the longer time of PLA degradation than that of our expectation. The blown plastic film that had been dried in an oven overnight to remove humidity was weighed to obtain the weight loss (Figure 2). The sampling time points are shown on the X-axis. The weight of both LDPE blown films that were floated on the seawater surface and submerged in the sand under the seawater increased slightly after 60 weeks of the experiment due to the additional weight of the algae attached on the surface of the LDPE blown film. Moreover, the PLA blown film in our experiment showed the same weight result because it was cracked into small pieces due to hydrolysis of the ester bond without degradation, while the weight of the PBS blown film was significantly reduced after 20 weeks, and degradation was complete after 50–60 weeks. It could be concluded that the PLA blown film would take longer than 100 weeks to biodegrade, and the PBS blown film could be degraded faster than the PLA blown film in the marine environment. In addition, the PLA and PBS blown films that were floated on the seawater surface would be degraded faster than those submerged in the sand under the seawater in our experimental setup, as seen in Tables 1, 2.
Table 1
| Low-density polyethylene(floating on the seawater) | Low-density polyethylene (submerging under the sand) | Polybutylene succinate (floating on the seawater) | Polybutylene succinate (submerging under the sand) | |
|---|---|---|---|---|
| Week 2 | ||||
|
|
|
|
|
| Week 22 | ||||
|
|
|
|
|
| Week 32 | ||||
|
|
|
|
|
| Week 54 |
|
|
N/A |
|
Observation of blown film that was floated on the seawater surface and submerged in the sand under the seawater of low-density polyethylene and polybutylene succinate.
N/A means no plastic piece could be observed.
Table 2
| Low-density polyethylene (floating on seawater) | Low-density polyethylene (submerged under the sand) | Polylactic acid (floating on seawater) | Polylactic acid (submerged under the sand) | |
|---|---|---|---|---|
| Week 2 | ||||
|
|
|
|
|
| Week 56 | ||||
|
|
|
|
|
| Week 66 | ||||
|
|
|
|
|
| Week 100 |
|
|
|
|
Observation of blown film that was floated on seawater surface and submerged in the sand under the seawater of low-density polyethylene and polylactic acid.
Figure 2

Weight of the sample blown films after having been dried in an oven.
The seawater containing PBS and PLA blown films in our experimental setup was sampled after the biodegradation of bioplastics to determine the particle size and particle size distribution of microplastics by using an optical microscope with image J software. Figure 3 shows the particle size distribution of PBS and PLA microplastics after biodegradation. The particle size distribution was calculated from 200 particles per sample using statistical methods. The particle size distribution of PBS microplastics that were floated on the seawater surface [PBS (W)] was smaller than that of PBS microplastics submerged in the sand under the seawater [PBS (S)]. The average arithmetic mean diameter ( ) of PBS (W) and PBS (S) microplastics were 3.5 and 7.75 μm, respectively, after 54 weeks in our experimental setup. Furthermore, the average arithmetic mean diameter ( ) of PLA microplastics that floated on the seawater [PLA (W)] and of PLA that was submerged in the sand under the seawater [PLA (S)] after 80 weeks (Figure 3) were 7.96 and 9.61 μm, respectively. The larger size of PLA microplastics compared to PBS microplastics was a result of the slower degradation rate of PLA blown film, as mentioned earlier. Moreover, PBS microplastics in the seawater disappeared after 100 weeks in our experimental setup. The change in the chemical functional groups of blown plastic film from our experimental setup was analyzed to explain the biodegradation mechanism of bioplastics in a marine environment.
Figure 3

Particle size distribution of microplastics that were floated on the seawater surface (W) and submerged in the sand under the seawater (S) after biodegradation.
Chemical analysis of biodegradable bioplastics
The chemical functional groups of the plastics were characterized by FTIR in ATR mode. Figure 4A shows the reference sample of LDPE blown film, which underwent no treatment, the LDPE blown film sample that was floated on the seawater surface, and the LDPE blown film sample that was submerged in the sand under the seawater. The result showed the same chemical functional groups in all samples of LDPE blown film due to the absence of degradation in a marine environment owing to the petroleum-based composition of this plastic type. The peak of the spectrum of LDPE blown film that was floated on the seawater surface at around 2,358 cm-1, which represented the C=C bonds in the LDPE structure, disappeared, and the small peak at around 2,635 cm-1, representing the aldehyde group (H-C=O), appeared. These results might be the effect of algae covering the surface of LDPE blown film after 100 weeks of our experimental setup, as seen in Table 2. Moreover, the chemical functional group of PBS and PLA blown films after biodegradation in a marine environment was determined, respectively. It was found from our results that the PBS blown film that was submerged in the sand under the seawater after 54 weeks of testing did not change its chemical structure compared to the reference sample of PBS blown film that was the plastic without experimental testing. By contrast, the chemical functional group of the PBS blown film that was floated on the seawater surface showed different results after 54 weeks. The result exhibited a new peak at around 1,470 cm-1, which was attributed to C-O-H stretching, and the peak at around 1,700 cm-1, which was the carboxylic group, disappeared, as seen in Figure 4B. These results might be due to the mechanism of hydrolysis of polybutylene succinate. In addition, the PLA blown film that was submerged in the sand under the seawater and the PLA blown film that floated on the seawater surface (Figure 4C) showed a new peak at 3,600 and 2,100 cm-1, compared to the PLA reference, which represented O–H stretching and C≡C stretching, This result might be due to the mechanism of polylactic acid hydrolysis under the seawater (Kim and Kim, 2008; Zumstein et al., 2016; Elsawy et al., 2017).
Figure 4

Chemical structure of plastic that was floated on the seawater surface (W) and submerged in the sand under the seawater (S) as measured by ATR-FTIR. (A) Low-density polyethylene, (B) polybutylene succinate, and (C) polylactic acid.
Seawater analysis after biodegradation of bioplastics
The BOD of seawater after the biodegradation test in the fish tank was analyzed after 54 and 80 weeks for PBS and PLA, respectively, to calculate the oxygen used by bioactive consumption in the seawater by these two films compared to the LDPE blown film under the same conditions of our experimental setup. The time of seawater sampling was different due to differences in the degradation rates of PBS and PLA blown films. In the LDPE experiment, seawater was sampled at 80 weeks to confirm that the BOD value was unchanged after a long testing duration. The BOD test was performed according to ISO 5815 standard. The results in Table 3 show the DO0, the DO5, and the difference between DO0 and DO5, referring to the BOD value at the first day of the test compared to the sample after incubation for 5 days at 20°C, respectively. The difference between these two values indicates the quantity of oxygen demanded for bioactive consumption, which relates to the oxygen used by bioactive and organic compounds in the seawater after biodegradation. Other researchers (Hakkarainen, 2002; Kim and Kim, 2008; Pelegrini et al., 2015; Zumstein et al., 2016; Elsawy et al., 2017) explained that the biodegradation mechanism begins with the absorption of water into the plastic film and hydrolysis by scissoring of the ester linkage of biodegradable polymers. Then, microorganisms initiate the colonization process for the biodegradation of bioactive substance in the seawater; thus, the oxygen used by bioactive consumption in the seawater should increase during biodegradation due to microbial processing. Our results found that the BOD value of the seawater in the PBS blown film test showed the highest value, followed by those of PLA and LDPE blown film, respectively. This was due to the high biodegradation rate of the PBS blown film after 54 weeks and that of PLA after 80 weeks in our experiment, while the LDPE blown film did not degrade until 100 weeks because it is petroleum-based and could not be degraded by bioactive substances. Thus, the BOD value after incubation of the seawater sampled from the LDPE blown film experiment should not change. To confirm this result, the seawater of our experiment was observed for bacteria that could use the oxygen in the seawater after the degradation of bioplastics. The results in Figure 5A show the bacterial growth in cell culture after incubation for 24 h. The type of bacteria was obtained by the dye staining method using an optical microscope (Beveridge, 2001; Giuliano et al., 2019; Skariyachan et al., 2021). The results in Figure 5B show a gram-negative bacteria, which might relate to bioactive consumption during the BOD test in our experiment.
Table 3
| Name | DO0mg/l | DO5mg/l | BODmg/l |
|---|---|---|---|
| Low-density polyethylene floating on seawater | 4.3 ± 0.3 | 5.2 ± 0.4 | 0.9 |
| Low-density polyethylene submerged under the sand | 4.3 ± 0.3 | 4.5 ± 0.2 | 0.2 |
| Polybutylene succinate floating on seawater | 6.1 ± 0.2 | 8.7 ± 0.2 | 2.6 |
| Polybutylene succinate submerged under the sand | 3.1 ± 0.1 | 5.3 ± 0.1 | 2.2 |
| Polylactic acid floating on seawater | 3.2 ± 0.1 | 4.4 ± 0.1 | 1.2 |
| Polylactic acid submerged under the sand | 3.2 ± 0.1 | 4.9 ± 0.5 | 1.7 |
Biochemical oxygen demand of the seawater after the biodegradability of bioplastics.
Figure 5
Growth of bacteria in the cell culture (A) and gram-negative bacteria observed under an optical microscope (B).
Conclusion
The biodegradability of PBS and PLA, respectively, was compared to that of LDPE, which is a petroleum-based plastic, in a marine environment. The results showed the biodegradability of PBS and PLA blown films floated on the seawater surface and submerged in the sand under the seawater. The PBS blown film that was floated on the seawater surface was degraded after 22 weeks, while the PBS blown film that was submerged in the sand under the seawater took a longer time, around 4–8 additional weeks. In addition, the PLA blown film cracked into small pieces after 56 and 66 weeks of floating on the seawater surface and submersion in the sand under the seawater, respectively. The LDPE blown film did not degrade within 100 weeks due to the lack of degradation characteristics of petroleum plastics. The weight of the plastic film after the degradation test showed different results among these three types of plastics. The weight of the LDPE blown film increased slightly because of algae accumulation onto the film surface, while the weight of PLA did not change because the PLA blown film was cracked into small pieces by a hydrolytic mechanism, and the sample had not been enough for a complete degradation test beyond our estimated degradation time. On the other hand, complete weight loss of the PBS blown film was obtained after 50–60 weeks in our experimental setup due to the rapid degradation rate of PBS blown film. The change in the chemical functional groups of PBS and PLA blown film plastics after degradation was due to a hydrolytic mechanism under the seawater and to bioactive consumption. The particle size of the microplastics of PBS was smaller than that of PLA microplastics after biodegradation as a result of the faster degradation rate. The microplastics of PBS in the seawater disappeared after 100 weeks, but unfortunately, the microplastics of PLA blown film did not completely degrade after 100 weeks.
Funding
We would like to acknowledge the National Research Council of Thailand and the Faculty of Engineering, Burapha University, Thailand, for financial support.
Publisher’s note
All claims expressed in this article are solely those of the authors and do not necessarily represent those of their affiliated organizations, or those of the publisher, the editors and the reviewers. Any product that may be evaluated in this article, or claim that may be made by its manufacturer, is not guaranteed or endorsed by the publisher.
Statements
Data availability statement
The original contributions presented in the study are included in the article/supplementary material. Further inquiries can be directed to the corresponding author.
Author contributions
All authors listed have made a substantial, direct, and intellectual contribution to the work and approved it for publication.
Conflict of interest
The authors declare that the research was conducted in the absence of any commercial or financial relationships that could be construed as a potential conflict of interest.
References
1
Akindele E. O. Alimba C. G. (2021). Plastic pollution threat in Africa: Current status and implications for aquatic ecosystem health. Environ. Sci. Pollut. Res.28 (7), 7636–7651. doi: 10.1007/s11356-020-11736-6
2
Alfaro-Núñez A. Astorga D. Cáceres-FarÃas L. Bastidas L. Soto Villegas C. Macay K. et al . (2021). Microplastic pollution in seawater and marine organisms across the tropical Eastern pacific and galápagos. Sci. Rep.11 (1), 6424. doi: 10.1038/s41598-021-85939-3
3
Avio C. G. Gorbi S. Regoli F. (2017). Plastics and microplastics in the oceans: from emerging pollutants to emerged threat. Mar. Environ. Res.128, 2–11. doi: 10.1016/j.marenvres.2016.05.012
4
Awuchi C. Awuchi C. (2019). Impacts of plastic pollution on the sustainability of seafood value chain and human health. J. Adv. Acad. Res.5(11), 46–138. Available at: https://www.ijaar.org/volume5-issue11/
5
Beveridge T. J. (2001). Use of the gram stain in microbiology. Biotech. Histochem.76 (3), 111–118. doi: 10.1080/bih.76.3.111.118
6
Borrelle S. B. Ringma J. Law K. L. Monnahan C. C. Lebreton L. McGivern A. et al . (2020). Predicted growth in plastic waste exceeds efforts to mitigate plastic pollution. Science369 (6510), 1515–1518. doi: 10.1126/science.aba3656
7
Bubpachat T. Sombatsompop N. Prapagdee B. (2018). Isolation and role of polylactic acid-degrading bacteria on degrading enzymes productions and PLA biodegradability at mesophilic conditions. Polym. Degrad. Stab.152, 75–85. doi: 10.1016/j.polymdegradstab.2018.03.023
8
Coleman F. Wehle D. H. S. (1984). Plastic pollution: A worldwide oceanic problem. Parks9, 9–12.
9
Elsawy M. A. Kim K.-H. Park J.-W. Deep A. (2017). Hydrolytic degradation of polylactic acid (PLA) and its composites. Renew. Sust. Energ. Rev.79, 1346–1352. doi: 10.1016/j.rser.2017.05.143
10
Eriksen M. Lebreton L. C. Carson H. S. Thiel M. Moore C. J. Borerro J. C. et al . (2014). Plastic pollution in the world's oceans: more than 5 trillion plastic pieces weighing over 250,000 tons afloat at sea. PLoS One9 (12), e111913. doi:Â 10.1371/journal.pone.0111913
11
Geyer R. Jambeck J. R. Law K. L. (2017). Production, use, and fate of all plastics ever made. Sci. Adv.3 (7), e1700782. doi:Â 10.1126/sciadv.1700782
12
Giuliano C. Patel C. R. Kale-Pradhan P. B. (2019). A guide to bacterial culture identification and results interpretation. P &T.44 (4), 192–200.
13
Hakkarainen M. (2002). Aliphatic polyesters: abiotic and biotic degradation and degradation products. in: Degradable aliphatic polyesters. Adv. Polym. Sci.157, 113–138. doi: 10.1007/3-540-45734-8_4
14
Haward M. (2018). Plastic pollution of the world’s seas and oceans as a contemporary challenge in ocean governance. Nat. Commun.9 (1), 667. doi: 10.1038/s41467-018-03104-3
15
Jambeck Jenna R. Geyer R. Wilcox C. Siegler Theodore R. Perryman M. Andrady A. et al . (2015). Plastic waste inputs from land into the ocean. Science347 (6223), 768–771. doi: 10.1126/science.1260352
16
Jouanneau S. Recoules L. Durand M. J. Boukabache A. Picot V. Primault Y. et al . (2014). Methods for assessing biochemical oxygen demand (BOD): A review. Water Res.49, 62–82. doi: 10.1016/j.watres.2013.10.066
17
Joyner C. C. Frew S. (1991). Plastic pollution in the marine environment. Ocean Dev. Int.22 (1), 33–69. doi: 10.1080/00908329109545949
18
Kasamesiri P. (2021). Assessment on microplastics contamination in freshwater fish: A case study of the ubolratana reservoir, Thailand. Int. J. GEOMATE, 20(77), 62–68. doi: 10.21660/2020.77.6108
19
Kim H. S. Kim H. J. (2008). Enhanced hydrolysis resistance of biodegradable polymers and bio-composites. Polym. Degrad. Stab.93 (8), 1544–1553. doi: 10.1016/j.polymdegradstab.2008.05.004
20
Klangnurak W. Chunniyom S. (2020). Screening for microplastics in marine fish of Thailand: The accumulation of microplastics in the gastrointestinal tract of different foraging preferences. Environ. Sci. Pollut. Res.27 (21), 27161–27168. doi: 10.1007/s11356-020-09147-8
21
Lau W. W. Y. Shiran Y. Bailey R. M. Cook E. Stuchtey M. R. Koskella J. et al . (2020). Evaluating scenarios toward zero plastic pollution. Science369 (6510), 1455–1461. doi: 10.1126/science.aba9475
22
Lebreton L. Slat B. Ferrari F. Sainte-Rose B. Aitken J. Marthouse R. et al . (2018). Evidence that the great pacific garbage patch is rapidly accumulating plastic. Sci. Rep.8 (1), 4666. doi:Â 10.1038/s41598-018-22939-w
23
Mallet B. Lamnawar K. Maazouz A. (2014). Improvement of blown film extrusion of poly(Lactic acid): Structure–processing–properties relationships. Polym. Eng. Sci.54 (4), 840–857. doi: 10.1002/pen.23610
24
Mizuno S. Maeda T. Kanemura C. Hotta A. (2015). Biodegradability, reprocessability, and mechanical properties of polybutylene succinate (PBS) photografted by hydrophilic or hydrophobic membranes. Polym. Degrad. Stab.117, 58–65. doi: 10.1016/j.polymdegradstab.2015.03.015
25
Mochane M. J. Magagula S. I. Sefadi J. S. Mokhena T. C. (2021). A review on green composites based on natural fiber-reinforced polybutylene succinate (PBS). Polymers13 (8), 1200.
26
Morawska M. Krasowska K. (2017). Degradability of polylactide films by commercial microbiological preparations for household composters. Pol. J. Chem. Technol.19, 44–48. doi: 10.1515/pjct-2017-0047
27
Mukheed M. Khan A. (2021). Pollution in Pakistan: environmental and health implications. J. Pollut. Effects Control.8, 251. doi:Â 10.35248/2375-4397.20.8.251
28
Muthuraj R. Misra M. Mohanty A. K. (2018). Biodegradable compatibilized polymer blends for packaging applications: A literature review. J. Appl. Polym. Sci.135 (24), 45726. doi:Â 10.1002/app.45726
29
Pahl S. Wyles K. J. Thompson R. C. (2017). Channelling passion for the ocean towards plastic pollution. Nat. Hum. Behav.1 (10), 697–699. doi: 10.1038/s41562-017-0204-4
30
Palai B. Mohanty S. Nayak S. K. (2020). Synergistic effect of polylactic acid(PLA) and poly(butylene succinate-co-adipate) (PBSA) based sustainable, reactive, super toughened eco-composite blown films for flexible packaging applications. Polym. Test.83, 106130. doi:Â 10.1016/j.polymertesting.2019.106130
31
Peelman N. Ragaert P. De Meulenaer B. Adons D. Peeters R. Cardon L. et al . (2013). Application of bioplastics for food packaging. Trends Food Sci. Technol.32 (2), 128–141. doi: 10.1016/j.tifs.2013.06.003
32
Pelegrini K. Donazzolo I. Brambilla V. Grisa A. Piazza D. Zattera A. et al . (2015). Degradation of PLA and PLA in composites with triacetin and buriti fiber after 600 days in a simulated marine environment. J. Appl. Polym. Sci.133, 43290. doi:Â 10.1002/app.43290
33
Rhodes C. J. (2018). Plastic pollution and potential solutions. Sci. Prog.101 (3), 207–260. doi: 10.3184/003685018X15294876706211
34
Ross P. S. Chastain S. Vassilenko E. Etemadifar A. Zimmermann S. Quesnel S.-A. et al . (2021). Pervasive distribution of polyester fibres in the Arctic oceanis driven by Atlantic inputs. Nat. Commun.12 (1), 106. doi:Â 10.1038/s41467-020-20347-1
35
Sigler M. (2014). The effects of plastic pollution on aquatic wildlife: Current situations and future solutions. Water Air Soil Pollut.225 (11), 2184. doi:Â 10.1007/s11270-014-2184-6
36
Skariyachan S. Taskeen N. Kishore A. P. Krishna B. V. Naidu G. (2021). Novel consortia of enterobacter and pseudomonas formulated from cow dung exhibited enhanced biodegradation of polyethylene and polypropylene. J. Environ. Manage.284, 112030. doi:Â 10.1016/j.jenvman.2021.112030
37
Stafford R. Jones P. S. (2019). Viewpoint – ocean plastic pollution: A convenient but distracting truth? Mar. Policy.103, 187–191. doi: 10.1016/j.marpol.2019.02.003
38
Su S. Kopitzky R. Tolga S. Kabasci S. (2019). Polylactide (PLA) and its blends with poly(butylene succinate) (PBS): A brief review. Polymers11 (7), 1193.
39
Vegter A. C. Barletta M. Beck C. Borrero J. Burton H. Campbell M. L. et al . (2014). Global research priorities to mitigate plastic pollution impacts on marine wildlife. Endanger Species Res.25 (3), 225–247.
40
Wabnitz C. Nichols W. (2010). Plastic pollution: An ocean emergency. Mar. Turtle Lett.20, 1–4.
41
Wilcox C. Mallos N. J. Leonard G. H. Rodriguez A. Hardesty B. D. (2016). Using expert elicitation to estimate the impacts of plastic pollution on marine wildlife. Mar. Policy.65, 107–114. doi: 10.1016/j.marpol.2015.10.014
42
Xu J. Guo B. H. (2010). Poly(butylene succinate) and its copolymers: research, development and industrialization. Biotechol. J.5 (11), 1149–1163. doi: 10.1002/biot.201000136
43
Yen F. S. Liao H. T. Wu C. S. (2013). Characterization and biodegradability of agricultural residue-filled polyester ecocomposites. Polym. Bull.70 (5), 1613–1629. doi: 10.1007/s00289-012-0862-3
44
Zumstein M. T. Kohler H. P. E. McNeill K. Sander M. (2016). Enzymatic hydrolysis of polyester thin films: Real-time analysis of film mass changes and dissipation dynamics. Environ. Sci. Technol.50 (1), 197–206. doi: 10.1021/acs.est.5b04103
Summary
Keywords
biodegradation, marine environment, polybutylene succinate, polylactic acid, blown film plastic
Citation
Phosri S, Kunjiek T, Mukkhakang C, Suebthep S, Sinsup W, Phornsirigarn S and Charoeythornkhajhornchai P (2022) Biodegradability of bioplastic blown film in a marine environment. Front. Mar. Sci. 9:917397. doi: 10.3389/fmars.2022.917397
Received
11 April 2022
Accepted
29 June 2022
Published
16 August 2022
Volume
9 - 2022
Edited by
Sedat Gundogdu, Çukurova University, Turkey
Reviewed by
Zhanyong Wang, Shenyang Agricultural University, China; Fathilah Ali, International Islamic University Malaysia, Malaysia
Updates
Copyright
© 2022 Phosri, Kunjiek, Mukkhakang, Suebthep, Sinsup, Phornsirigarn and Charoeythornkhajhornchai.
This is an open-access article distributed under the terms of the Creative Commons Attribution License (CC BY). The use, distribution or reproduction in other forums is permitted, provided the original author(s) and the copyright owner(s) are credited and that the original publication in this journal is cited, in accordance with accepted academic practice. No use, distribution or reproduction is permitted which does not comply with these terms.
*Correspondence: Pollawat Charoeythornkhajhornchai, pollawat.ch@eng.buu.ac.th
This article was submitted to Marine Pollution, a section of the journal Frontiers in Marine Science
Disclaimer
All claims expressed in this article are solely those of the authors and do not necessarily represent those of their affiliated organizations, or those of the publisher, the editors and the reviewers. Any product that may be evaluated in this article or claim that may be made by its manufacturer is not guaranteed or endorsed by the publisher.